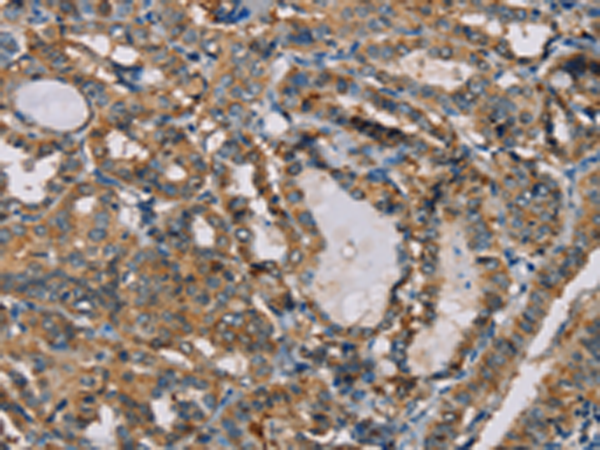

中文名稱:兔抗CENPU多克隆抗體
英文名稱: Anti-CENPU rabbit polyclonal antibody
別 名: KLIP1; PBIP1; CENP50; MLF1IP; CENPU50
相關類別: 一抗
儲 存: 冷凍(-20℃)
宿 主: Rabbit
抗 原: CENPU
反應種屬: Human
標 記 物: Unconjugate
克隆類型: rabbit polyclonal
技術規(guī)格
|
Background: |
The centromere is a specialized chromatin domain, present throughout the cell cycle, that acts as a platform on which the transient assembly of the kinetochore occurs during mitosis. All active centromeres are characterized by the presence of long arrays of nucleosomes in which CENPA (MIM 117139) replaces histone H3 (see MIM 601128). MLF1IP, or CENPU, is an additional factor required for centromere assembly. |
|
Applications: |
ELISA, IHC |
|
Name of antibody: |
CENPU |
|
Immunogen: |
Fusion protein of human CENPU |
|
Full name: |
centromere protein U |
|
Synonyms: |
KLIP1; PBIP1; CENP50; MLF1IP; CENPU50 |
|
SwissProt: |
Q71F23 |
|
ELISA Recommended dilution: |
1000-2000 |
|
IHC positive control: |
Human thyroid cancer and Human brain |
|
IHC Recommend dilution: |
25-100 |
購物車
幫助
021-54845833/15800441009
